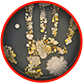

This End User License Agreement is concluded between you, the User, the Advertiser and the CPA
network.
User is a person who through the activities of the CPA network is attracted by promotion
methods to purchase/sell the offers for goods and/or services provided by an Advertiser, with the
intention to order or acquire, or use the goods exclusively for personal, family, home and other
needs not related to the implementation of entrepreneurial activities.
Advertiser is a person who wants to place an offer in a CPA network to sell a particular
product and/or service.
CPA network (abbreviation from Cost Per Action, that means payment for the action) is an
electronic business environment in the course of which a relationship is established between an
Advertiser and a CPA network, by virtue of which an Advertiser offers the product and/or services,
and a CPA network, in turn, attracts users interested in acquiring offers, allowed by the Advertiser
methods. The end result of such activity is the purchase of the goods and/or services by users
through the CPA network.
Parties are a User, an Advertiser, and a CPA network.
Website is an internet resource of the web store that has the domain name h.Retoxin-new.com,
which is under organizational management and belongs to the Advertiser under the terms of private
property rights.
Public offer is a proposal addressed to an undefined circle of persons or to several specific
persons, which specifically expresses the intention of the person who made the offer to consider
himself/herself to have entered into this End User License Agreement with the addressee that will
accept the offer.
Acceptance – full acceptance by one of the Parties of the conditions of the public offer of
the CPA network for the conclusion of this end user license agreement. Acceptance of a public offer
occurs when the site is launched (including for informational purposes) and its services are used.
1. General provisions
1.1. This End User License Agreement (hereinafter referred to as the “Agreement”)
defines the general rules for visiting, using the services and the general rules of conduct on the
Website of the User and regulates the civil and legal relations that are formed between the User and
the Advertiser, as well as the User, the Advertiser and the CPA network in the process of their
interaction.
1.2. This Agreement may be amended by a decision of the CPA network and/or the
Advertiser unilaterally. The CPA-network and/or the Advertiser does not bear the obligation of
personal notification of the User about such changes. The new version of the Agreement shall enter
into force from the time of purchase of the goods/services of the Advertiser by the User.
1.3. The terms of the Agreement are applicable to all website clients without
exception.
1.4. The User starting using the Website confirms the fact that he has familiarized himself with the
provisions of this Agreement in his right mind and with clear memory, understands them fully and
accepts the conditions for using the website to full extent. If there is a disagreement with the
provisions of this Agreement (partially or in whole), the person expressing such will is not
entitled to use the information field of the Website.
2. Regulation of the interaction of the parties
2.1. The implementation of services and/or capabilities provided by the Website
does not give the User any exclusive rights and privileges.
2.2. The Parties to this Agreement have agreed that the CPA network is entitled to
post advertisement units and banners in any of its fields, including the places where information is
published by the User without the additional consent of the User.
2.3. The information posted on the Website by the CPA network is the result of the
intellectual activity of the CPA network and all proprietary and personal non-property rights to
such information are owned by the CPA network until it is determined otherwise. At the same time,
the User does not have any exclusive rights to the result of intellectual activity of the CPA
network expressed in graphic, text, audio-video form placed by the CPA network on the Website.
2.4. The CPA network is not obligated to protect the violated rights of the User in
the context of settlement of disputes arising on this ground, including judicial manner.
2.5. The CPA network is not the owner/manufacturer of the goods and/or services
posted on the Website and is not responsible for the violation of the User's rights. The purpose of
the CPA network under this agreement is to attract potential users interested in acquiring goods
and/or services authorized by the Advertiser by methods. The end result of such activity is the
purchase of the goods and/or services by the User through the CPA network.
2.6. Violation by the User or the Advertiser of copyrights belonging to the CPA
network and (or) other persons, entails for the offender liability provided for by the provisions of
the current legislation of the Russian Federation.
2.7. In case of revealing infringement of copyrights by the User, by illegal
placement of materials not belonging to the User, the CPA network withdraws such materials from free
access at the first request of the legal right holder.
2.8. The User is prohibited from posting on the Website information that directly
or indirectly contains the generally accepted signs of pornography, insulting, prejudicing, damaging
someone else's dignity, containing calls for violence, brutality and other actions that lead to
violations of the laws in force, certain territorial jurisdictions, containing malicious software
and (or) other information that may harm third parties.
2.9. In the event of violation of the conditions of 2.8. of this Agreement and the
failure to comply with the requirements of the CPA network, including the withdrawal of such
information from public access, the Website's users are liable under the provisions of this
Agreement and (or) the current legislation of the Russian Federation. The CPA network is then
entitled to remove the information mentioned in paragraph 2.8.
2.10. The CPA network is not responsible for the results of a User's visit to
third-party (external) resources that can be posted on the Website. Results mean any results,
regardless of its nature, as well as the one from which the User incurred any material losses, moral
damage and other negative manifestations.
2.11. The procedure for remote trading, the rights and obligations of the Parties to the agreement,
as well as third parties, specific requirements for the processes of interaction between the Parties
and the design of advertising sites, are subject to the regulatory order by the Federal Law “On
Advertising”, the Rules for Remote Trading approved by the Resolution of the Government of the
Russian Federation No 612 as of 27.09.2007, as well as other normative acts and this Agreement.
3. Rights and obligations of the Advertiser
3.1. The Advertiser is obliged to offer the User a service to deliver the goods by
mail or transport, indicating the mode of delivery and mode of transport used.
3.2. The Advertiser is obliged to inform the User about the need to call for help
of the qualified specialists for connecting, setting up and commissioning technically complex
products, which cannot be put into operation without the participation of competent specialists in
accordance with technical requirements.
3.3. The Advertiser is not entitled to perform additional works (services) for
payment without the consent of the User.
3.4. Before the conclusion of the contract of retail sale (hereinafter referred to
as the “Contract”) the Advertiser is obliged to provide the User with information about the basic
consumer properties of the goods and the address (location) of the Advertiser, about the place of
manufacture of the goods, the full name of the Advertiser, the price and conditions of the purchase
contract of goods, its delivery, service life, shelf life and warranty period, the procedure for
payment for the goods, as well as the period during which the proposal to enter into the contract is
valid.
3.5. The Advertiser at the time of delivery of the goods is obliged to inform the
User in writing the following information (for imported goods - in Russian):
3.5.1. the name of the technical regulation or other symbol established by the
legislation of the Russian Federation on technical regulation and indicating the mandatory
confirmation of the conformity of the goods;
3.5.2. information on the main consumer properties of the goods (works, services),
and with respect to foodstuffs - information on the composition (including the names of food
additives used in the process of food production, biologically active additives, information on the
presence in food products of components obtained with application of genetically engineered
organisms), nutritional value, purpose, conditions of application and storage of food products,
methods of making ready meals, weight (volume), date and place of manufacture and packaging of food,
as well as information on contraindications for their use in certain diseases;
3.5.3. price in rubles and conditions for the acquisition of the goods (work
performance, services);
3.5.4. information on warranty period, if any;
3.5.5. rules and conditions for the efficient and safe use of goods;
3.5.6. information on the service life or the expiration date of the goods, as well
as information about the necessary actions of the User after the expiration of the specified terms
and possible consequences if such actions are not performed, if the goods after the expiration of
the indicated periods pose a danger to the life, health and property of the Client or become
unsuitable for intended use;
3.5.7. location (address), company name of the manufacturer (the Advertiser),
location (address) of the company(s) authorized by the manufacturer (the Advertiser) to accept
claims from the User and perform repair and maintenance of the goods, for the imported goods -
country name of the origin of the goods; (see the text in the previous wording)
3.5.8. information on mandatory confirmation of the conformity of goods (services)
with compulsive requirements ensuring their safety for life, health of the User, the environment and
prevention of damage to the User's property in accordance with the legislation of the Russian
Federation;
3.5.9. information on the rules for the sale of the goods (performance of work,
provision of services);
3.5.10. information about the specific person who will perform the work (provide
the service) and information about him, if relevant, it is based on the nature of the work
(services);
3.5.11 information on the energy efficiency of the goods for which the requirement
for the availability of such information is determined in accordance with the legislation of the
Russian Federation on energy conservation and on improving energy efficiency.
3.6. The Advertiser is obliged to provide information to the User if the goods
purchased by the User were in use or in which the deficiency was eliminated.
3.7. The Advertiser is obliged to inform the User about the goods, including the
maintenance conditions and the storage rules, which are communicated to the Customer by placing on
the product, on electronic carriers, attached to the goods, in the product itself (on the electronic
board inside the goods in the menu section), on the packaging, label, marking, in technical
documentation or in any other way established by the legislation of the Russian Federation.
3.8. The Advertiser is obliged to inform the User about the period during which the
offer to sell the goods/services on the website is in effect.
3.9. The Advertiser has the both right to accept and to reject the User's offer to
forward the goods by postal mail way “to be called for”.
3.10. The Advertiser shall ensure the confidentiality of personal data about the
User in accordance with the legislation of the Russian Federation in the field of
confidentiality.
3.11. The Advertiser provides the User with catalogs, booklets, pamphlets,
photographs or other information materials containing full, reliable and accessible information
characterizing the offered goods.
3.12. If the User refuses the goods, the Advertiser is obliged to return to him the
amount paid by the User in accordance with the Contract, with the exception of the Advertiser's
expenses for the delivery of the returned goods from the User not later than 10 days from the date
of presentation of the relevant demand by the User.
3.13. In the event that the Agreement is concluded on the condition that the goods
are delivered to the User, the Advertiser shall deliver the goods to the place specified by the User
within the period established by the Contract, and if the place of delivery of the goods is not
specified by the User, then to the place of his residence.
3.14. The Advertiser shall deliver the goods to the User in the order and time
specified in the Contract.
3.15. The Advertiser is obliged to deliver to the User the goods, the quality of
which corresponds to the Contract and the information provided to the User at the conclusion of the
Contract, as well as information brought to its attention when transferring the goods (in technical
documentation attached to the product, on labels, by marking or by other means provided for certain
types of the goods).
3.16. If the Advertiser when concluding the Contract was informed by the User of
the specific purposes for the purchase of the goods, the Advertiser is obliged to transfer to the
User the goods suitable for use in accordance with these purposes.
3.17. The costs of the refund of the amount paid by the User in accordance with the
Contract shall be borne by the Advertiser.
3.18. Payment for the goods by the User by transferring funds to the account of a third party
indicated by the Advertiser does not relieve the Advertiser of the obligation to return the amount
paid by the User when the goods are returned by the User both of proper and improper quality.
4. Rights and obligations of the User
4.1. The User has the right to refuse the goods at any time prior to its transfer
and after the transfer of the goods - within 7 days.
4.2. The User has the right to refuse the goods within 3 months from the moment of
transfer of the goods, in the event that information on the procedure and terms for returning the
goods of the proper quality were not provided in writing at the time of delivery of the goods.
4.3. Return of good quality goods is possible in the event that marketable
condition, consumer properties are preserved, as well as a document confirming the fact and
conditions for the purchase of the said goods. The User's lack of this document does not deprive him
of the opportunity to refer to other evidence of the purchase of goods from this Advertiser.
4.4. The User shall not be entitled to refuse from the goods of proper quality,
having individually defined properties, if the specified goods can only be used by the User who
acquires them.
4.5. The User is obliged to re-pay the cost of delivery services, if the delivery
of the goods is made within the terms established by the Contract, but the goods were not
transferred to the User through his fault, the subsequent delivery is made in a new time agreed with
the Advertiser.
4.6. In the event that the goods are transferred to the User in violation of the
terms of the Contract concerning the quantity, assortment, quality, completeness, boxes and (or)
packaging of the goods, the User may notify the Advertiser of such violations within 20 days after
receipt of the goods.
4.7. If deficiencies in the goods are found in respect of which the warranty terms
or expiration dates are not established, the User shall be entitled to present claims in respect of
defects of the goods within a reasonable time, but within 2 years from the date of its transfer to
the User, longer periods are not established by regulatory acts or the Contract.
4.8. The User has the right to present requirements to the Advertiser in respect of
defects of the goods, if they are revealed during the warranty period or the expiration date.
4.9. The User who is sold the goods of inadequate quality, if this was not agreed
by the Advertiser, has the right at his choice to demand:
a) free elimination of defects of the goods or compensation of expenses for their
correction by the User or the third party;
b) a proportionate reduction in the purchase price;
c) the replacement of a similar brand (model, item) or other brand (model, item)
with the corresponding recalculation of the purchase price. However, in the case of technically
complex and expensive goods, these requirements of the User are to be met if significant
deficiencies are discovered.
4.10. The User instead of claiming the requirements specified in clause 4.9 of this
Agreement, has the right to refuse to perform the Contract and demand the return of the amount paid
for the purchased goods. At the request of the Advertiser and at its expense, the User shall return
the item with defects.
4.11. The User has the right to demand full compensation for losses caused to him
by the sale of the goods of inadequate quality. The losses are reimbursed within the time limits
established by the Law of the Russian Federation “On Protection of Consumer Rights” to meet the
relevant requirements of the User.
4.12. The User has the right to refuse to execute the Contract and demand
compensation for the losses caused, if the Advertiser fails to transfer the goods.
4.13. When returning goods of inadequate quality, the User's lack of a document
confirming the fact and conditions for the purchase of the goods does not deprive him of the
opportunity to refer to other evidence of the purchase of the goods from the Advertiser.
4.14. Refusal or evasion of the Advertiser from drawing up the waybill or the
certificate does not deprive the User of the right to demand the return of the goods and (or) return
of the amount paid by the User in accordance with the Contract.
4.15. The User has the right to refuse to pay for additional works (services) that
are not stipulated by the Contract, and if they are paid, the User has the right to demand from the
Advertiser a refund paid above the specified amount.
4.16. In case of using the results of the intellectual property of the CPA network;
the materials of the Website, for any purpose, the User shall obtain the permission of the CPA
network before placing such materials. Given the permission of the CPA network, the User shall
display the full name and domain name of the source in the following format: web store
h.Retoxin-new.com. The hyperlink is to be active and direct, when clicked on a transition a
particular page of the Website is opened from which the material is borrowed.
4.17. By analogy with the instructions set out in p. 4.16. of this Agreement, the User undertakes to
act, in the case of using the results of intellectual property, that it belongs to third parties.
The method and procedure of implementation are specified in the process of negotiations with the
owner of the materials.
5. Liability of the partiesLiability of the parties
5.1. The CPA network is not responsible for the actions of the User that have
violated the rights of the third parties, except in the case of certain existing legislation of the
Russian Federation.The CPA network is not responsible for the actions of the User that have violated
the rights of the third parties, except in the case of certain existing legislation of the Russian
Federation.
5.2. The CPA network is not responsible for the content of the information placed
by the Advertiser and/or the User.The CPA network is not responsible for the content of the
information placed by the Advertiser and/or the User.
5.3. The CPA network is not responsible for the content of Website feedback. The
feedback of users from the website is subjective opinion of their authors, which is in no way
intended to be objective. They may not coincide with public opinion and do not correspond to
reality.The CPA network is not responsible for the content of Website feedback. The feedback of
users from the website is subjective opinion of their authors, which is in no way intended to be
objective. They may not coincide with public opinion and do not correspond to reality.
5.4. The decision on the issue/non-issuance of personal data is accepted by the CPA
network only on the basis of a request sent by the person of the CPA network in accordance with the
procedure established by applicable law.The decision on the issue/non-issuance of personal data is
accepted by the CPA network only on the basis of a request sent by the person of the CPA network in
accordance with the procedure established by applicable law.
5.5. CPA network has the right not to respond to inquiries, appeals and letters
that do not contain requisites of the contacting person (full name, contact details).CPA network has
the right not to respond to inquiries, appeals and letters that do not contain requisites of the
contacting person (full name, contact details).
5.6. CPA network is not responsible for the registration data, which was indicated
by the User when interacting with the information field of the Website.CPA network is not
responsible for the registration data, which was indicated by the User when interacting with the
information field of the Website.
5.7. CPA network has the right to limit without explanation of reasons, to block the User's access
(including unregistered one) to the Website, with partial or complete removal of information that
was posted by the User on the Website. CPA network undertakes to review the claim, executed in
accordance with the procedure provided for by section 5 of the Agreement within 30 (thirty) calendar
days from the date of receipt.CPA network has the right to limit without explanation of reasons, to
block the User's access (including unregistered one) to the Website, with partial or complete
removal of information that was posted by the User on the Website. CPA network undertakes to review
the claim, executed in accordance with the procedure provided for by section 5 of the Agreement
within 30 (thirty) calendar days from the date of receipt.
6. Dispute settlement procedureDispute settlement procedure
6.1. In case of posted information on the Website containing the results of
intellectual property owned by the third parties, the copyright owner is obliged to:In case of
posted information on the Website containing the results of intellectual property owned by the third
parties, the copyright owner is obliged to:
6.1.1. Draw up a claim indicating the actual and regulatory grounds that enable the
CPA network to withdraw information from public access.Draw up a claim indicating the actual and
regulatory grounds that enable the CPA network to withdraw information from public access.
6.1.2. Attach to the claim evidence for the originality of the result of
intellectual property (original copy, other documents confirming the right of ownership of the
copyright object).Attach to the claim evidence for the originality of the result of intellectual
property (original copy, other documents confirming the right of ownership of the copyright
object).
6.1.3. Send the package of documents mentioned in the provisions of subparagraphs
6.1.1., 6.1.2. of this Agreement to the electronic mail of the CPA network:
[email protected] the package of documents mentioned in the provisions of subparagraphs
6.1.1., 6.1.2. of this Agreement to the electronic mail of the CPA network:
[email protected]
6.2. The claims of the User on the quality of service, products, as well as other comments, should be
sent to the Advertiser on the electronic mail: [email protected] claims of the User on the
quality of service, products, as well as other comments, should be sent to the Advertiser on the
electronic mail: [email protected]
7. MiscellaneousMiscellaneous
7.1. All possible situations, disputes arising out of the relationship between the
User and the Advertiser, as well as the User, the Advertiser and the CPA network, which are not
settled by this Agreement, shall be resolved in accordance with the rules of the current legislation
of the Russian Federation.All possible situations, disputes arising out of the relationship between
the User and the Advertiser, as well as the User, the Advertiser and the CPA network, which are not
settled by this Agreement, shall be resolved in accordance with the rules of the current legislation
of the Russian Federation.
7.2. The Parties to this Agreement are aware of the scope of the rights and
obligations generated by the relationships of the persons mentioned in this Agreement and realize
their actions, understand the legal nature of the consequences of such actions to full extent.The
Parties to this Agreement are aware of the scope of the rights and obligations generated by the
relationships of the persons mentioned in this Agreement and realize their actions, understand the
legal nature of the consequences of such actions to full extent.
7.3. Omission to act on the part of the CPA network in case of violation of the
provisions of the Agreement by any of the Users does not deprive the CPA network of the right to
take later appropriate actions in defense of its interests and protection of the rights protected by
the law.Omission to act on the part of the CPA network in case of violation of the provisions of the
Agreement by any of the Users does not deprive the CPA network of the right to take later
appropriate actions in defense of its interests and protection of the rights protected by the
law.
7.4. The Advertiser's contact information:The Advertiser's contact information:

Anna, 47 éves
A gyomrom még soha nem fájt. Nem ettem olyat, ami szokatlan, és hirtelen fájdalom és puffadás jelent meg. Az orvos azt mondta, hogy összeszedtem valami parazitákat és felírta a Retoxin kezelésre és az azt követő megelőzésre. Minden a helyére állt és olyan lett, mint korábban!
Gábor, 79 éves
Minél idősebb lesz az ember, annál érzékenyebben reagál a szervezete a változásokra. Lehetetlen meglátni a parazitákat, de a fertőzés után rettenetes viszketés kezdődik. Ezt lehetetlen elviselni, tehát mindig fel vagyok fegyverkezve egy biztonságos gyógyszerrel - Retoxin.
Valéria, 29 éves
Nagyon szeretem a sushit, és egyszer már felszedtem a helmintot (a sushiba nyers hal van). Retoxin kezeltem ki magam. Nem tudok teljesen lemondani a kedvenc ételemről, ezért időszakosan iszom ezeket a kapszulákat, hogy megvédjem magam.